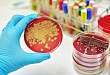
他汀类或是控制金葡菌感染的新帮手

-

-
2018.03.30重磅:CHMP 认同依洛尤单抗可预防心肌梗死和脑卒中
依洛尤单抗产品标签推荐新增适应症是基于 Repatha 心血管结局研究 (FOURIER) 的研究结果。
-

-
2018.02.242018 你一定要知道:8 位专家总结的心血管笔记
第五届阿斯利康心血管高峰论坛上,心血管及内分泌领域大咖云集,高朋满座,共话学界最新动态,传递诊疗观点。现在就将这份满满的干货总结于此,2018 你一定用得上!
-

-
2018.01.11病例分享:乱舞的主动脉内血栓
主动脉内长了血栓,还不脱落,什么情况?
-

-
2018.01.08高血压指南更新只和医生有关?这 4 大点护士不可不知
美国高血压指南更新了,中国护士应该怎样对待?
-
-
2017.11.30他汀类或是控制金葡菌感染的新帮手
他汀类药物除了可以调节血脂、抗动脉粥样硬化、保护血管外,其多效性已得到证实。动脉粥样硬化和菌血症之间具有相似的病理生理过程,他汀类药物可能对治疗菌血症有效。
-

-
2017.11.18Anacetrapib 有效降低动脉粥样硬化患者心血管事件
REVEAL 研究 III 期临床研究结果表明 CETP 抑制剂 Anacetrapib 进一步降低动脉粥样硬化患者心血管事件,全文发表在 NEJM 上。
-

-
2017.10.18口诀 3 则:轻松搞定老年高血压用药
随着我国步入老龄化社会,临床医生面对的老年高血压患者越来越多,那么该类患者在调控血压方面与普通患者有何不同?老年高血压治疗药物应如何选择呢?
-

-
2017.10.18长城会 2017:中国特色的心血管病风险评估方案
心血管病是多个危险因素共同作用的结果,每个个体发生心血管病的风险不仅取决于某一个危险因素的水平,还取决于个体同时具有的危险因素的数目和水平。
-

-
2017.10.14长城会 2017:怎样管理及控制盐敏感高血压
食盐摄入过多引发高血压,该怎么办?
-

-
2017.10.09LDL-C 降脂靶标有望进一步下调
Giugliano 博士等研究发现,LDL-c 水平越低,其心血管获益越大,研究结果发表在 THE LANCET 杂志上。
